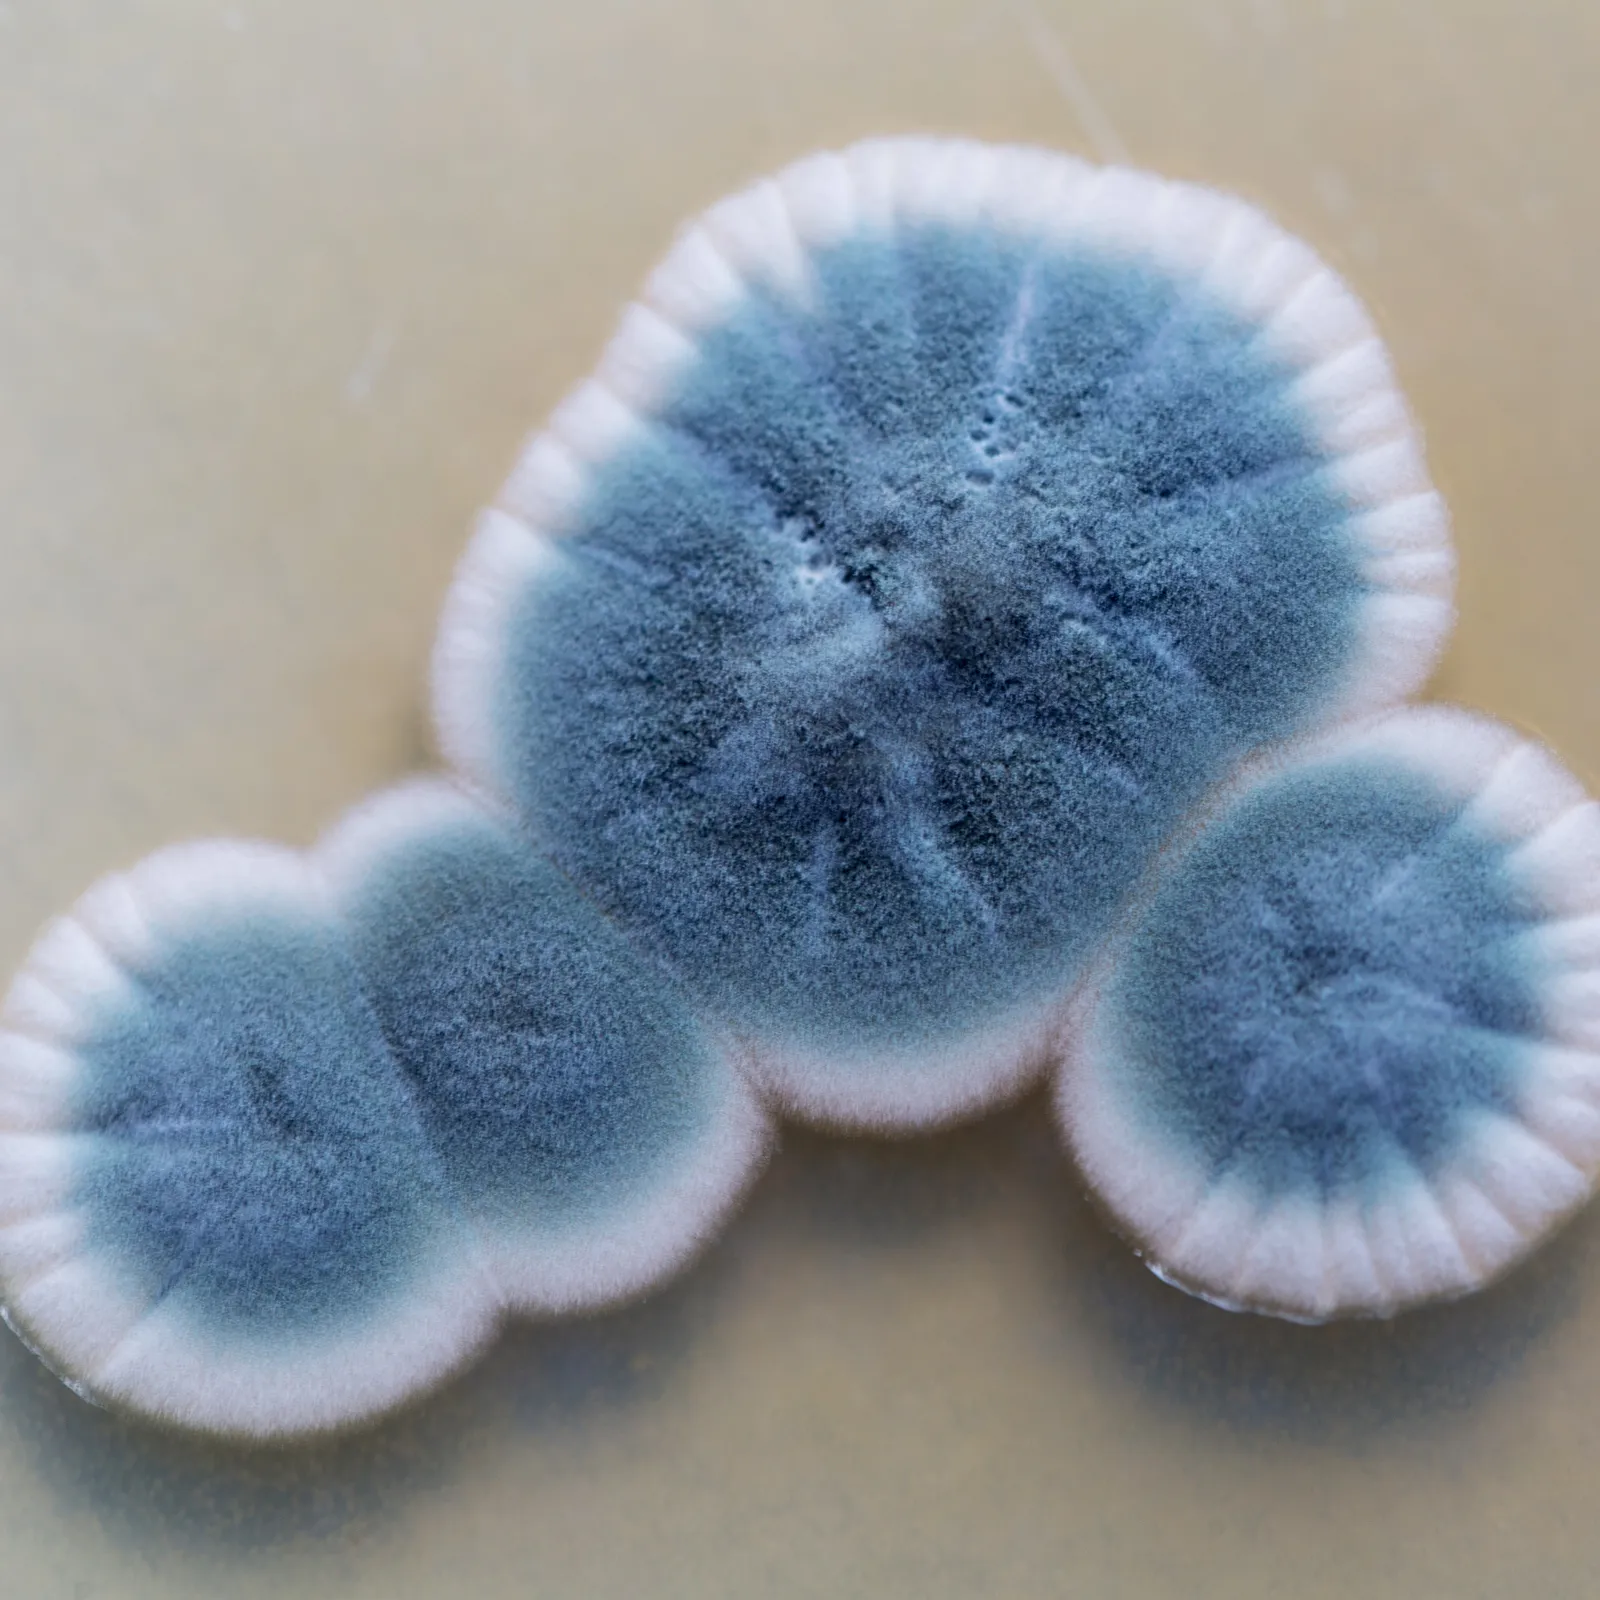
About Image

Is Mold Effecting Your Health?
Not feeling like yourself lately? Mold in your home or business may be the hidden cause. Nearly 47% of U.S. homes show signs of visible mold or mold odor, and exposure can create underlying health issues. When spores spread indoors, they contaminate the air you breathe and may trigger a variety of symptoms. Homeowners across Southeast Michigan often face hidden mold problems that, if left untreated, can lead to ongoing health concerns. Recognizing the signs early is the key to protecting your family and restoring safe indoor air quality.